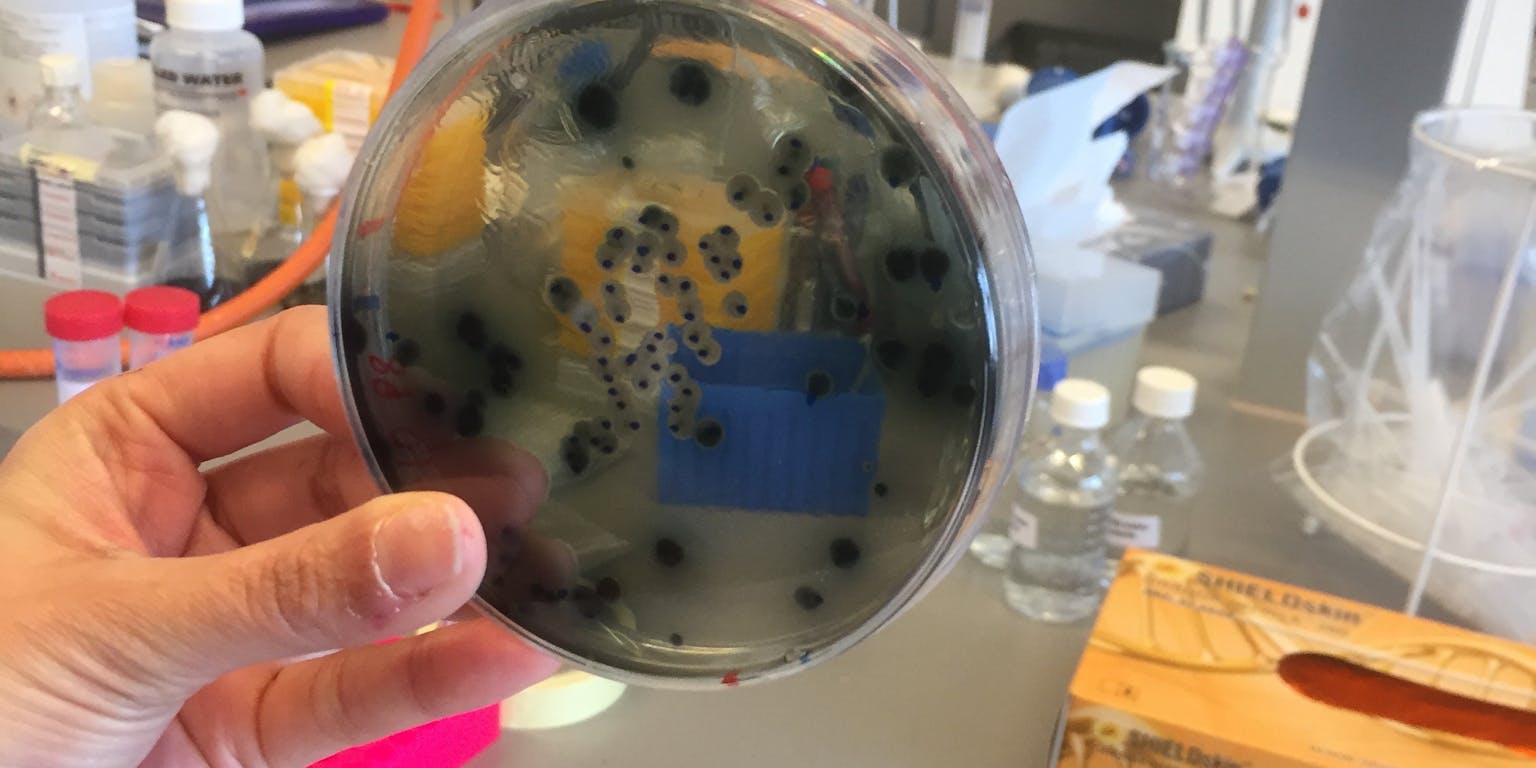

Hoe zag het eerste leven eruit? Er is nog veel onbekend over de allereerste cellen. NEMO Kennislink interviewde Shraddha Shitut over haar onderzoek naar het delen van oercellen.
Hoe slaagden de allereerste cellen erin hun genetisch materiaal goed door te geven aan hun nakomelingen? Shraddha Shitut is postdoctoraal onderzoeker aan de Universiteit Leiden, waar ze werkt aan het onderzoeksprogramma van het Origins Center. Zij probeert een model te maken voor de deling van oercellen. Daarvoor moet tijdens de celdeling het DNA netjes in twee identieke porties worden verdeeld.
Hoe maak je van een moderne bacterie een primitieve cel?
“Een bacterie heeft een celwand en een celmembraan. In de cel zit het genetisch materiaal, het DNA, strak opgerold in de vorm van chromosomen. Als een cel gaat delen, zijn er veel eiwitten betrokken bij het bepalen van het punt waar de splitsing van de cel plaats gaat vinden. De eiwitten helpen ook met het gelijk verdelen van de chromosomen over de nieuwe cellen. De meeste van die eiwitten binden op een specifieke plaats aan de celwand. De celwand is dus belangrijk om de celdeling goed te laten verlopen.”

Deze cellen zijn rond, omdat ze geen celwand meer hebben. De vloeistof in de cel is rood en het DNA is groen. Door de kleuring kan Shitut volgen hoe het DNA verdeeld wordt als een cel zich splitst.
Minesweerperonline.com“De allereerste cellen hadden waarschijnlijk nog geen celwand. Als je de celwand van een moderne bacterie verwijdert, verliest de bacterie zijn typische staafvorm en wordt bolvormig. Aan de buitenkant zit een enkellaags celmembraan, zoals een vetbubbel in water. Als zo’n cel gaat delen is er geen celwand meer die aanwijst waar de cel in tweeën moet splitsen, en welke kant de chromosomen op moeten. De eiwitten die normaal helpen bij het splitsen, kunnen zich nergens meer aan vast grijpen. De splitsing gebeurt dan min of meer willekeurig. Ik probeer een primitief celmodel te maken voor de deling van het genetisch materiaal. Ik probeer uit te vinden of – en hoe – het primitieve cellen lukt om in twee gelijke dochtercellen te splitsen.”
Waar komt je interesse in dit onderwerp vandaan?
“Tijdens mijn promotieonderzoek werkte ik met cross-feeding in bacteriën. In een groep groeien bacteriën niet onafhankelijk van elkaar: ze hebben allerlei interacties met elkaar. Dat kunnen negatieve interacties zijn, bijvoorbeeld het produceren van giftige stoffen om andere cellen te doden, of positieve interacties, bijvoorbeeld het uitwisselen van cruciale voedingstoffen die de bacteriën nodig hebben om in leven te blijven. Aminozuren zijn de bouwstenen van eiwitten en zijn daarom van levensbelang voor de cel. Ik onderzocht of de bacteriën elkaar in leven konden houden als zij zelf een bepaald aminozuur niet meer konden produceren, maar hun buurman wel.”
“Ik keek naar twee specifieke aminozuren, histidine en tryptofaan. De ene bacterie kon geen histidine produceren, de andere geen tryptofaan. De bacteriën werkten samen door hun aminozuren uit te wisselen. Ik vind het fascinerend hoe individuele cellen samen kunnen werken. Er is in de wereld een hoop egocentrisch gedrag, ook bij mensen, maar als je om je heen kijkt zie je overal samenwerking. Ik wilde weten of die samenwerkingsfilosofie ook opgaat voor genen. Want genen zijn uiteindelijk de eenheid van de evolutionaire selectie.”
Hoe onderzoek je dat precies?
“In een cel zijn er twee kopieën aanwezig van één chromosoom. Mijn idee is om de chromosomen aan te passen, zodat de ene kopie geen genetische informatie meer heeft om histidine te maken en de andere kopie de informatie mist om tryptofaan te maken. De chromosomen moeten dan samenwerken, zodat de cel zowel tryptofaan als histidine kan maken. Als de cel splitst en de twee dochtercellen krijgen elk allebei de chromosomen, dan kan de cel allebei de aminozuren maken, en dan blijft de cel leven. Als een dochtercel maar één van de chromosomen krijgt, mist hij de informatie om het andere aminozuur te maken, en sterft.”
En nu ben je bezig om zo’n cel te maken?
“Ja. We kunnen nu al goed cellen maken zonder celwand, maar als die delen, wordt hun DNA willekeurig verdeeld over de dochtercellen. We moeten dus uitzoeken hoe de chromosomen verdeeld worden. Dat doen we door onderdelen van de cel een kleurtje te geven. Het cytoplasma, de vloeistof in de cel, laten we rood oplichten en het chromosoom groen. Onder de microscoop kun je dan zien hoeveel groene stipjes er in de rode stipjes zitten – dus hoeveel chromosomen er in een cel aanwezig zijn.”
“Het is gelukt om cellen met twee verschillende chromosomen te maken. Het is nog niet gelukt om ervoor te zorgen dat de cel geen tryptofaan en geen histidine kan maken – dat is nu de grootste horde. Het probleem is dat als ik het gen verwijder, de cellen nog steeds kunnen groeien op een voedingsbodem zonder die twee aminozuren. Dat betekent dat de cellen nog steeds die twee aminozuren aanmaken, want anders zouden ze sterven. Het zou kunnen dat er andere genen zijn die de aminozuurproductie overnemen. Dat ben ik nu aan het onderzoeken.”

Shraddha Shitut bij de microscoop.
Esther Thole voor NEMO KennislinkAls dat lukt heb je een modelsysteem voor primitieve celdeling op de plank staan. En dan, wat kan je daar vervolgens mee?
“We kunnen de cellen onder druk van antibiotica laten groeien. Treden er bijvoorbeeld grote veranderingen op in het DNA? Zo krijgen we een beeld van de verschillende eiwitten en andere moleculen die een rol spelen bij de celdeling. We kunnen precies bijhouden welke veranderingen optreden en wanneer ze optreden, en welke veranderingen tegelijkertijd optreden om er zeker van te zijn dat de celdeling steeds goed blijft verlopen. Zo komen we erachter welke genen absoluut nodig zijn voor de celdeling.”
“Als we dat eenmaal weten, kunnen we kijken of die genen ook voorkomen in andere soorten uit andere takken van het leven, om te zien of die ook sporen hebben van deze genen. Als dat zo is, mag je aannemen dat die genen heel lang geleden al bestonden en bewaard zijn gebleven gedurende de evolutie. Zo kunnen we er achter te komen hoe het DNA van oercellen eruit moet hebben gezien.”